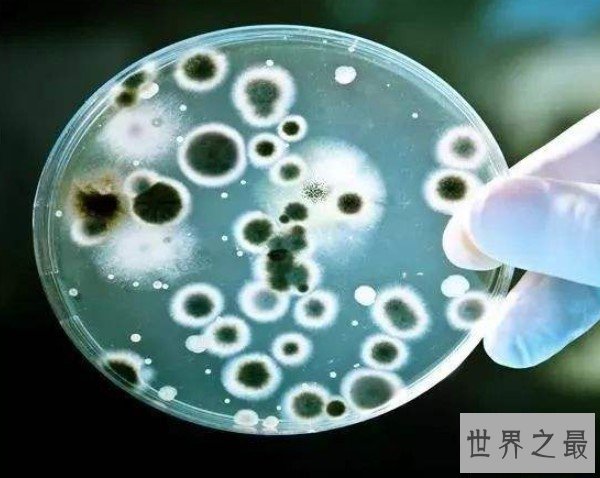
世界上细菌最多的水果，每个苹果携带的细菌高达1亿个
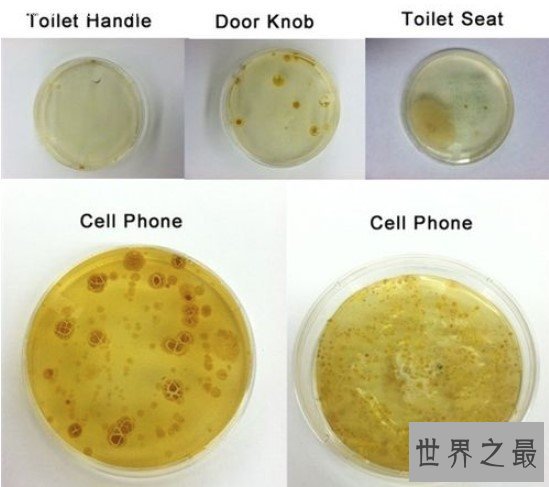
世界上细菌最多的水果，每个苹果携带的细菌高达1亿个
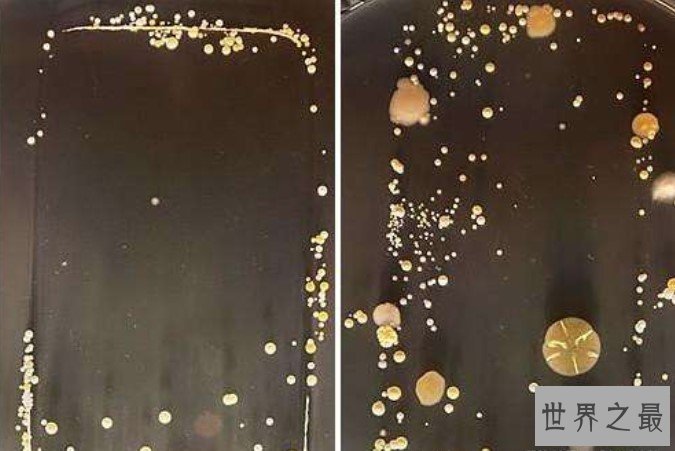
世界上细菌最多的水果，每个苹果携带的细菌高达1亿个

苹果是我们日常生活中不可或缺的美味水果,每个人都知道吃前应该仔细清洗。但你知道吗,除了纤维、黄酮类化合物外,每个苹果携带的细菌高达1亿个。这是好事吗?可能如此,但这可能取决于苹果是如何培育的。
一项新研究显示,有机苹果拥有更多样化、更平衡的细菌群落,这可能使它们比传统苹果更健康、更美味,而且对环境也更有利。 这项研究的资深作者、奥地利格拉茨理工大学的加布里埃尔·伯格教授(Gabriele Berg)说:“我们食物中的细菌、真菌和病毒会短暂地在我们的肠道中定植。烹饪杀死了大部分细菌,所以生水果和蔬菜是肠道微生物的重要来源。” 为了帮助我们明智地选择结肠“殖民者”,伯格的团队分析了世界上最受欢迎的水果之一——苹果所携带的微生物群。 伯格说:“2018年苹果产量达到8300万个,而且产量还在继续增长。虽然最近的研究已经绘制出了它们的真菌含量,但对苹果中细菌的了解却很少。”
这项研究的资深作者、奥地利格拉茨理工大学的加布里埃尔·伯格教授(Gabriele Berg)说:“我们食物中的细菌、真菌和病毒会短暂地在我们的肠道中定植。烹饪杀死了大部分细菌,所以生水果和蔬菜是肠道微生物的重要来源。” 为了帮助我们明智地选择结肠“殖民者”,伯格的团队分析了世界上最受欢迎的水果之一——苹果所携带的微生物群。 伯格说:“2018年苹果产量达到8300万个,而且产量还在继续增长。虽然最近的研究已经绘制出了它们的真菌含量,但对苹果中细菌的了解却很少。” 研究人员将传统商店购买的苹果与新鲜有机苹果中的细菌进行了比较。茎、果皮、果肉、种子和花萼(花底部的散乱部分)分别进行了分析。 总的来说,有机苹果和传统苹果被相似数量的细菌所占据。 伯格说:“把每个苹果成分的平均值加在一起,我们估计一个典型的240克苹果携带大约1亿个细菌。”其中大部分细菌都在种子中,剩下的大部分在果肉中。所以,如果你丢弃了果核,你摄入体内的细菌量会下降到接近1000万。 伯格解释说:“与传统的苹果相比,新鲜采摘的有机苹果拥有更多样化、更均匀和更独特的细菌群落。”
研究人员将传统商店购买的苹果与新鲜有机苹果中的细菌进行了比较。茎、果皮、果肉、种子和花萼(花底部的散乱部分)分别进行了分析。 总的来说,有机苹果和传统苹果被相似数量的细菌所占据。 伯格说:“把每个苹果成分的平均值加在一起,我们估计一个典型的240克苹果携带大约1亿个细菌。”其中大部分细菌都在种子中,剩下的大部分在果肉中。所以,如果你丢弃了果核,你摄入体内的细菌量会下降到接近1000万。 伯格解释说:“与传统的苹果相比,新鲜采摘的有机苹果拥有更多样化、更均匀和更独特的细菌群落。” 伯格指出:“这种多样性和平衡有望限制任何一个物种的过度生长,而此前的研究报告显示,人类病原体的丰富程度与新鲜农产品的微生物群多样性呈负相关。” 以对健康有潜在影响而闻名的特定细菌群也更多倾向存在于有机苹果中。举例来说,细菌Escherichia-Shigella中包括许多已知的病原体,它们存在于大多数传统的苹果样品中,但在有机苹果中却没有发现。而有益的乳酸菌(益生菌)则恰好相反。甲状杆菌(可以促进草莓风味化合物的生物合成)在有机苹果中明显更丰富,尤其是在果皮和果肉样本上,这些样本的微生物群比种子、茎或花萼更多样化。
伯格指出:“这种多样性和平衡有望限制任何一个物种的过度生长,而此前的研究报告显示,人类病原体的丰富程度与新鲜农产品的微生物群多样性呈负相关。” 以对健康有潜在影响而闻名的特定细菌群也更多倾向存在于有机苹果中。举例来说,细菌Escherichia-Shigella中包括许多已知的病原体,它们存在于大多数传统的苹果样品中,但在有机苹果中却没有发现。而有益的乳酸菌(益生菌)则恰好相反。甲状杆菌(可以促进草莓风味化合物的生物合成)在有机苹果中明显更丰富,尤其是在果皮和果肉样本上,这些样本的微生物群比种子、茎或花萼更多样化。 这些研究结果反映了苹果真菌群落的发现。该研究的主要作者比尔吉特·沃瑟曼(Birgit Wasserman)评论道:“我们的研究结果与最近一项关于苹果果实相关真菌群落的研究惊人地一致,该研究揭示了真菌品种对不同组织和管理实践的特异性。” 这些研究表明,无论是细菌还是真菌,苹果的微生物群在有机水果中都更加多样化。由于另一项研究表明,苹果真菌群落也具有品种特异性,因此在其他品种中也应重复进行细菌分析。
这些研究结果反映了苹果真菌群落的发现。该研究的主要作者比尔吉特·沃瑟曼(Birgit Wasserman)评论道:“我们的研究结果与最近一项关于苹果果实相关真菌群落的研究惊人地一致,该研究揭示了真菌品种对不同组织和管理实践的特异性。” 这些研究表明,无论是细菌还是真菌,苹果的微生物群在有机水果中都更加多样化。由于另一项研究表明,苹果真菌群落也具有品种特异性,因此在其他品种中也应重复进行细菌分析。 沃瑟曼说:“新鲜农产品的微生物群落和抗氧化成分将来可能会成为标准的营养信息,与大量营养素、维生素和矿物质一起展示,以指导消费者购买。在这方面,关键将是确定食品微生物群的多样性在多大程度上能转化为肠道微生物多样性和改善健康结果。”
沃瑟曼说:“新鲜农产品的微生物群落和抗氧化成分将来可能会成为标准的营养信息,与大量营养素、维生素和矿物质一起展示,以指导消费者购买。在这方面,关键将是确定食品微生物群的多样性在多大程度上能转化为肠道微生物多样性和改善健康结果。”
免责声明:本站所有资源均来自网络,仅供学习交流使用!
